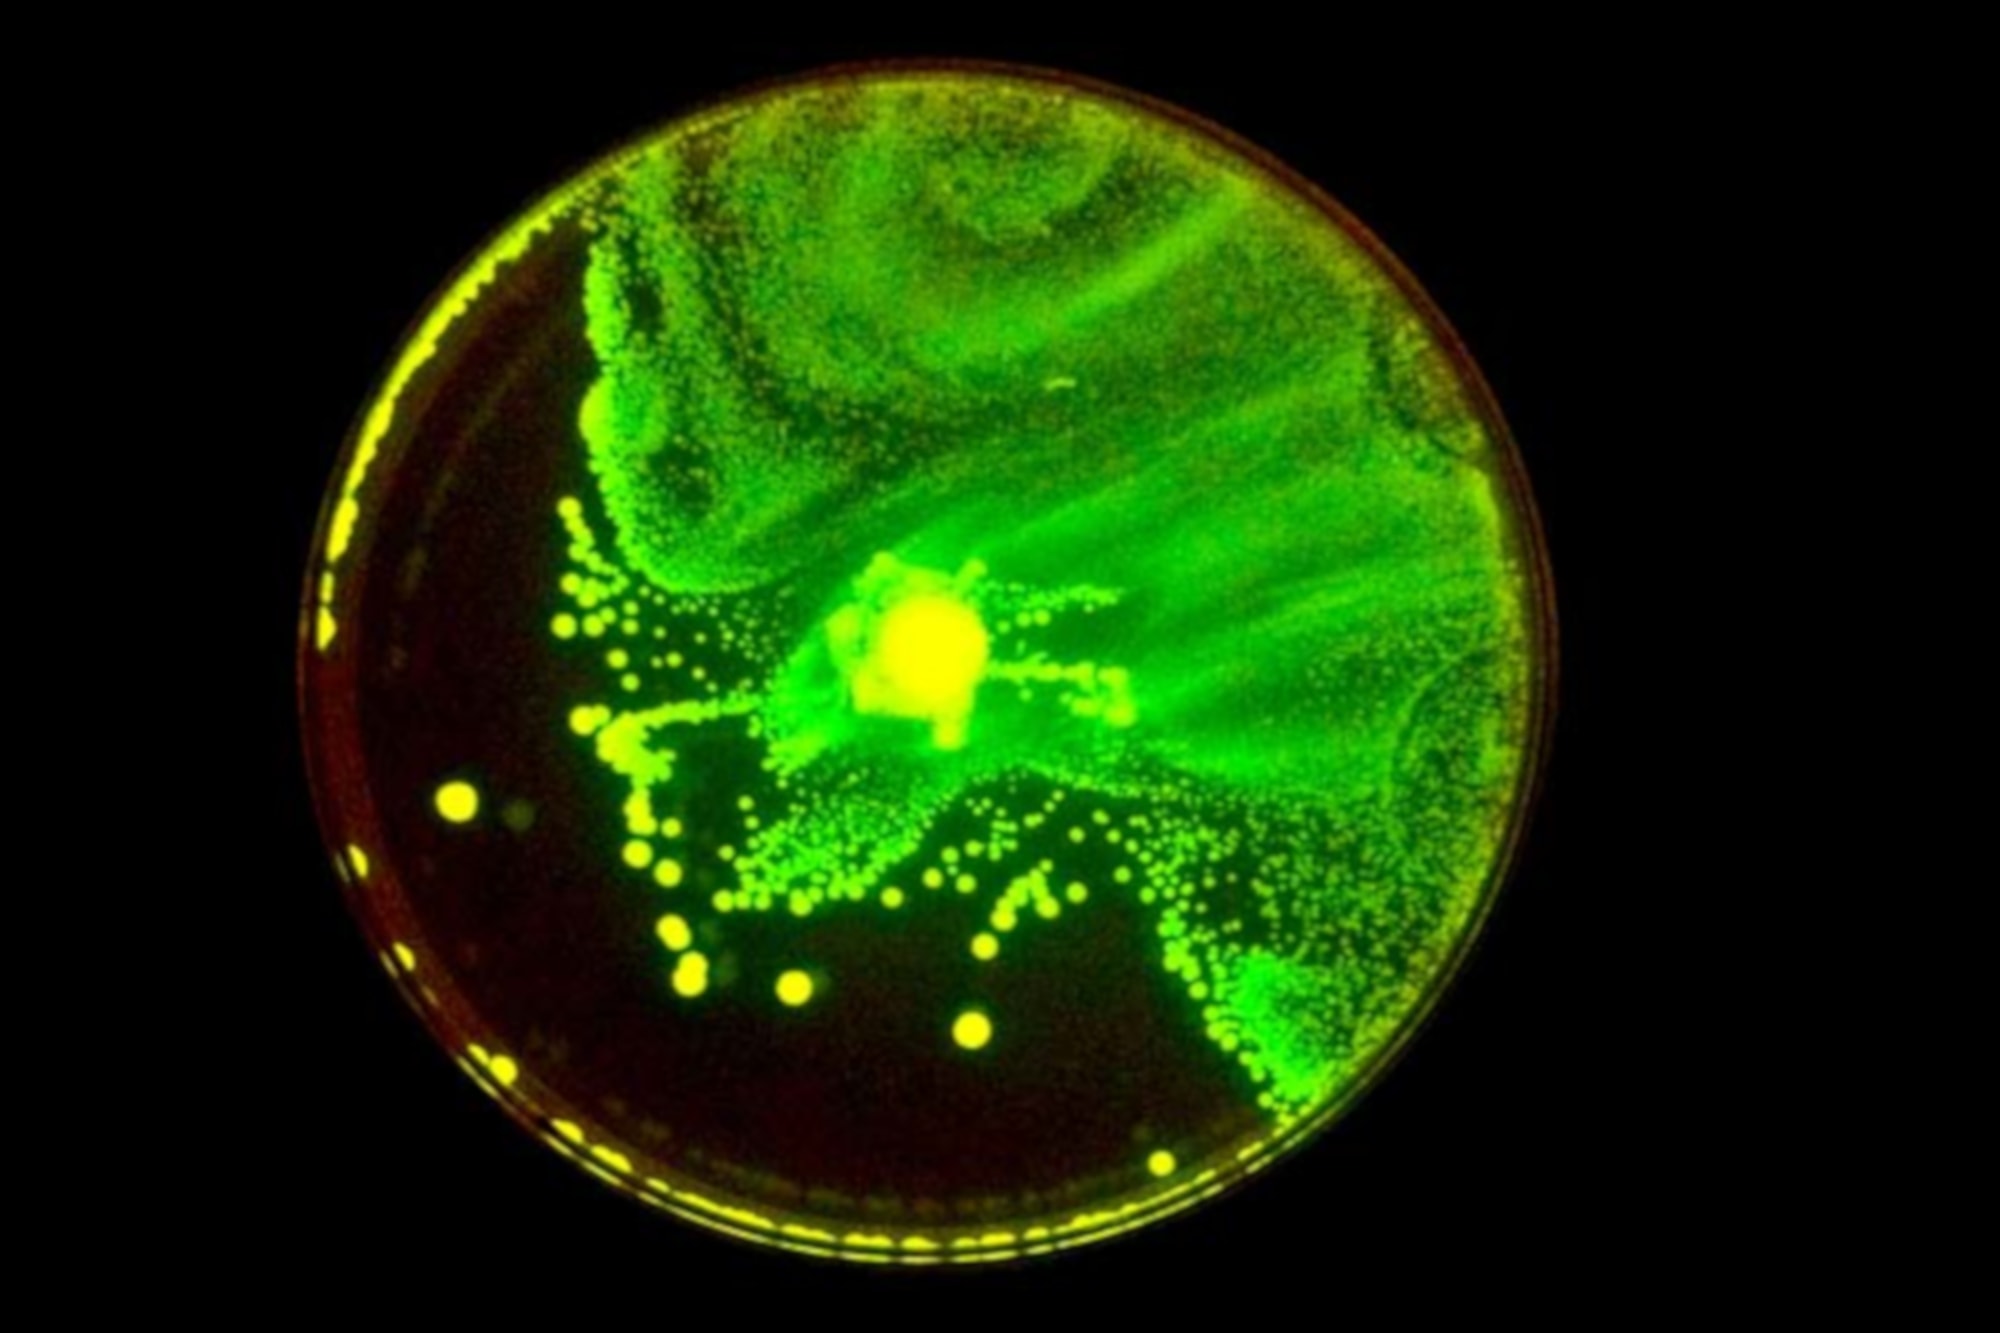

Synthetic Biology Workshop
C-LAB
Art Laboratory Berlin, in cooperation with Desiree Förster and Daniela Silvestrin, invite you to a workshop on Synthetic Biology by the artist collective C-LAB (UK).
C-LAB is a London based collective founded by Laura Cinti and Howard Boland which critically deals with the contemporary overlapping of art, science and technology. The focus of Cinti and Boland’s work is the investigation and exploration of the meaning and characteristics of all that relates to organic and synthetic life. Their concern here is to create a platform for both artistic and scientific reflection and discussion. In their current experimental art projects C-LAB have developed several genetic constructs that lead to novel behavior in E. coli bacteria; the artists explore the possibilities offered of synthetic biology and genetic engineering techniques in an art context (e.g. in artworks such kate, katEred, Stressostat and Banana Bacteria).
This workshop is for artists, designers, DIY biologists, and especially lay people who wish to gain practical experience with the processes and methods in the creation of new life forms, bio-materials and new forms of expression. During the workshop’s three days C-LAB shows, within a complete cycle of operation, how new forms of expression can be integrated into bacteria by genetic engineering and standardized synthetic biology. The aim is not only to test how parts can be interchanged easily by means of standardized genetic engineering, but the participants also attempt the production of genetic biosensors.
The workshop takes place partly in a makeshift (DIY) laboratory (on the premises of Art Laboratory Berlin), and partly in a professional laboratory for molecular biology. The participants are encouraged “to get their hands dirty” during the workshop and work with professional equipment in both an artistic and scientific context. The results and experiences are then reflected and discussed together with the artists, and both the artistic and the specific scientific practices are discussed from different points of view.



















